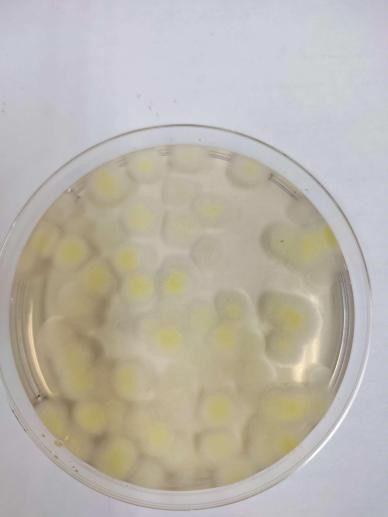
c

- 首頁(yè)
- 我們的服務(wù)
-
項(xiàng)目簡(jiǎn)介
醫(yī)療器械檢測(cè)是確保產(chǎn)品安全、有效與合規(guī)的關(guān)鍵環(huán)節(jié),涵蓋性能驗(yàn)證、材料安全及生物相容性測(cè)試,旨在預(yù)防潛在風(fēng)險(xiǎn),保護(hù)患者健康,推動(dòng)行業(yè)持續(xù)發(fā)展。
服務(wù)項(xiàng)目
醫(yī)用敷料類、醫(yī)用輸注器具及醫(yī)用導(dǎo)管類、藥械組合醫(yī)療器械、醫(yī)美產(chǎn)品
服務(wù)優(yōu)勢(shì)
資質(zhì)完備:已獲得國(guó)家CMA、省級(jí)CMA及CNAS資質(zhì),檢測(cè)結(jié)果權(quán)威可靠。
項(xiàng)目全面:提供理化/微生物檢測(cè)、生物相容性研究(依據(jù)GB/T 16886/ISO 10993)及臨床前功能性評(píng)價(jià)的一站式服務(wù)。
專業(yè)團(tuán)隊(duì):擁有經(jīng)驗(yàn)豐富的檢測(cè)隊(duì)伍,精通各類醫(yī)療器械標(biāo)準(zhǔn)與流程,確保高效精準(zhǔn)服務(wù)。
風(fēng)險(xiǎn)控制:通過(guò)體外/體內(nèi)實(shí)驗(yàn)綜合評(píng)價(jià)產(chǎn)品安全性,助力產(chǎn)品合規(guī)上市,提升市場(chǎng)競(jìng)爭(zhēng)力。
-
服務(wù)簡(jiǎn)介
華微檢測(cè)是由廣州高新區(qū)投資集團(tuán)直屬單位聯(lián)合華南新藥創(chuàng)制中心及海歸技術(shù)團(tuán)隊(duì)共同建設(shè)的第三方檢測(cè)機(jī)構(gòu),專注生物安全、生物醫(yī)藥與動(dòng)物實(shí)驗(yàn)等領(lǐng)域。我們搭建生物制品分析檢測(cè)綜合平臺(tái),嚴(yán)格遵循ISO/IEC17025體系,已獲國(guó)家CMA和CNAS認(rèn)證,提供符合《中國(guó)藥典》要求的細(xì)胞系/株全面檢定服務(wù),適用于抗體、重組蛋白、疫苗、細(xì)胞基因治療產(chǎn)品等生物制品的合規(guī)報(bào)批。
服務(wù)項(xiàng)目
細(xì)胞庫(kù)檢測(cè)、生物制品批放行檢查/型式檢查、細(xì)胞內(nèi)外源病毒因子檢查、原輔料/培養(yǎng)基/耗材檢查、工藝雜質(zhì)殘留研究、微生態(tài)制劑(活菌制劑)檢查
服務(wù)優(yōu)勢(shì)
權(quán)威資質(zhì):通過(guò)CMA、CNAS認(rèn)證,實(shí)驗(yàn)室符合GMP體系,檢測(cè)結(jié)果具法律效力和國(guó)際公信力。
高標(biāo)準(zhǔn)實(shí)驗(yàn)室:配備多間加強(qiáng)型P2實(shí)驗(yàn)室(廣州市備案),B+A環(huán)境,滿足無(wú)菌及病毒檢測(cè)要求。
法規(guī)符合性強(qiáng):嚴(yán)格遵循FDA、CHP、EP、ICH等國(guó)際國(guó)內(nèi)法規(guī),建立全面細(xì)胞庫(kù)檢定流程。
專業(yè)團(tuán)隊(duì)與技術(shù):依托高水平技術(shù)團(tuán)隊(duì)和完備操作規(guī)程,為客戶提供精準(zhǔn)、高效的生物制品檢測(cè)服務(wù)。
-
服務(wù)簡(jiǎn)介
我司提供全面的藥代藥效學(xué)研究評(píng)價(jià)服務(wù)。我們嚴(yán)格遵循NMPA、FDA和ICH相關(guān)技術(shù)指導(dǎo)原則,為客戶提供符合申報(bào)要求的全套體內(nèi)外評(píng)價(jià)模型與試驗(yàn)數(shù)據(jù)支持。
服務(wù)項(xiàng)目
藥代動(dòng)力學(xué)研究、 藥效學(xué)研究、皮膚外用試劑透皮吸收研究
服務(wù)優(yōu)勢(shì)
綜合平臺(tái):整合藥代、藥效及透皮研究能力,提供從體外到體內(nèi)的一體化評(píng)價(jià)方案。
專業(yè)團(tuán)隊(duì):擁有經(jīng)驗(yàn)豐富的研究人員,精通各類藥物劑型與模型的評(píng)價(jià)標(biāo)準(zhǔn)與法規(guī)要求。
先進(jìn)設(shè)備:配備LC-MS/MS、高效滲透系統(tǒng)等先進(jìn)儀器,保證數(shù)據(jù)精準(zhǔn)、可靠。
合規(guī)高效:實(shí)驗(yàn)過(guò)程嚴(yán)格遵循GLP規(guī)范,支持國(guó)內(nèi)外注冊(cè)申報(bào),加速產(chǎn)品研發(fā)與上市進(jìn)程。
-
服務(wù)簡(jiǎn)介
華微檢測(cè)提供專業(yè)的藥品及原輔料質(zhì)量研究與檢測(cè)分析服務(wù),配備精密儀器實(shí)驗(yàn)室、核磁共振實(shí)驗(yàn)室及多類先進(jìn)分析設(shè)備,涵蓋理化性質(zhì)分析、雜質(zhì)研究、含量測(cè)定及方法開發(fā)與驗(yàn)證等項(xiàng)目,全面支持藥品研發(fā)、生產(chǎn)及注冊(cè)申報(bào)的質(zhì)量控制需求。
服務(wù)項(xiàng)目
藥品/原輔料理化檢查、藥品微生物檢查、效價(jià)與生物學(xué)活性、生物安全性檢測(cè)(生物制品)、抗菌/抗病毒藥物篩選
服務(wù)優(yōu)勢(shì)
設(shè)備先進(jìn)齊全:配置HPLC、LC-MS、GC-MS、ICP-MS、AAS、酶標(biāo)儀等多類型高端儀器,保證檢測(cè)數(shù)據(jù)精準(zhǔn)可靠。
技術(shù)能力深厚:具備藥品及原輔料方法開發(fā)與驗(yàn)證經(jīng)驗(yàn),可提供從常規(guī)檢測(cè)到復(fù)雜研究的全流程解決方案。
定制化服務(wù):依據(jù)企業(yè)實(shí)際需求,提供靈活、高效的定制化開發(fā)與檢測(cè)服務(wù),助力企業(yè)加速研發(fā)進(jìn)程。
平臺(tái)資源豐富:依托完備的實(shí)驗(yàn)室平臺(tái)和專業(yè)團(tuán)隊(duì),能夠同時(shí)應(yīng)對(duì)多品類、多標(biāo)準(zhǔn)的藥品質(zhì)量評(píng)價(jià)任務(wù)
-
服務(wù)簡(jiǎn)介
新型冠狀病毒疫情嚴(yán)重危害人類健康,已成為全球關(guān)注的公共衛(wèi)生問題。抗病毒材料作為一種重要的防護(hù)手段,可有效抑制和殺滅病毒,但其實(shí)際效果需通過(guò)專業(yè)檢測(cè)驗(yàn)證。 隨著疫情防控常態(tài)化,市場(chǎng)對(duì)消毒及健康防護(hù)產(chǎn)品的需求持續(xù)增長(zhǎng),相關(guān)企業(yè)對(duì)于產(chǎn)品檢測(cè)的需求也日益迫切。 華微檢測(cè)為企業(yè)提供抗病毒材料及病毒消殺產(chǎn)品的專業(yè)檢測(cè)服務(wù),助力產(chǎn)品有效性驗(yàn)證,為公共健康保駕護(hù)航。
服務(wù)項(xiàng)目
凈化產(chǎn)品病毒去除性能測(cè)試、消毒產(chǎn)品病毒滅活效果測(cè)試、日化輕工材料抗病毒效果測(cè)試、精品定制化服務(wù)
服務(wù)優(yōu)勢(shì)
精英團(tuán)隊(duì),背景多元:技術(shù)團(tuán)隊(duì)由廣微所、華南新藥創(chuàng)制中心、高校重點(diǎn)實(shí)驗(yàn)室人員及病毒學(xué)領(lǐng)域海歸博士專家組成,結(jié)構(gòu)合理、實(shí)戰(zhàn)經(jīng)驗(yàn)豐富。
頂尖設(shè)備,科研級(jí)服務(wù):依托先進(jìn)硬件設(shè)施與高層次科研隊(duì)伍,在常規(guī)檢測(cè)中提供深度、沉浸式的科研體驗(yàn)。
靈活定制,一站式支持:除標(biāo)準(zhǔn)化測(cè)試外,支持各類客供實(shí)驗(yàn)方案,為產(chǎn)品開發(fā)與課題研究提供精品化、全方位技術(shù)服務(wù)。
-
服務(wù)簡(jiǎn)介
食品保健品檢測(cè)是通過(guò)理化、微生物與毒理學(xué)等方法,對(duì)食品及保健品的成分、安全性、功效及標(biāo)簽合規(guī)性進(jìn)行全面分析的科學(xué)過(guò)程。 我們致力于通過(guò)檢測(cè)重金屬、農(nóng)殘、微生物等風(fēng)險(xiǎn)物質(zhì),保證產(chǎn)品安全;驗(yàn)證有效成分與宣稱功能,確保功效可信
服務(wù)項(xiàng)目
食品保健品毒理學(xué)檢測(cè)、食品保健品功效評(píng)價(jià)研究、其它定制化服務(wù)
服務(wù)優(yōu)勢(shì)
符合國(guó)家標(biāo)準(zhǔn)與國(guó)際法規(guī),助力市場(chǎng)準(zhǔn)入; 具第三方檢測(cè)報(bào)告,增強(qiáng)消費(fèi)者信任,提升產(chǎn)品競(jìng)爭(zhēng)力。
- 化妝品原料毒理檢測(cè)
- 化妝品體外功效評(píng)價(jià)
- 化妝品/美容儀體內(nèi)外透皮吸收評(píng)價(jià)
- 實(shí)驗(yàn)動(dòng)物飼/寄養(yǎng)服務(wù)
- 動(dòng)物誘發(fā)性造模
- 儀器設(shè)備共享服務(wù)
- 分子生物學(xué)實(shí)驗(yàn)技術(shù)服務(wù)平臺(tái)
- ELISA實(shí)驗(yàn)技術(shù)服務(wù)
- 熒光定量PCR實(shí)驗(yàn)技術(shù)服務(wù)
- Western Blotting實(shí)驗(yàn)技術(shù)服務(wù)
- 外源性生物殘留檢測(cè)服務(wù)平臺(tái)
- 病毒核酸參考品服務(wù)
-
華微檢測(cè)除核心檢測(cè)服務(wù)外,還可提供以下延伸技術(shù)支持:專業(yè)實(shí)驗(yàn)空間租賃、定制化實(shí)驗(yàn)方案設(shè)計(jì)、規(guī)范化的實(shí)驗(yàn)動(dòng)物代養(yǎng) 實(shí)驗(yàn)方案設(shè)計(jì)是決定科研成敗與數(shù)據(jù)可靠性的關(guān)鍵環(huán)節(jié)。我們憑借專業(yè)團(tuán)隊(duì)和豐富經(jīng)驗(yàn),協(xié)助客戶根據(jù)研究目標(biāo)與條件,設(shè)計(jì)科學(xué)、嚴(yán)謹(jǐn)、可操作的實(shí)驗(yàn)方案,為項(xiàng)目順利開展提供堅(jiān)實(shí)基礎(chǔ)。
- 新聞資訊
- 檢測(cè)流程
- 下載中心
- 關(guān)于我們
- 聯(lián)系我們
 新聞資訊INFORMATION CENTER細(xì)胞庫(kù)檢定中外申報(bào)差異分析系列一:微生物檢查篇
新聞資訊INFORMATION CENTER細(xì)胞庫(kù)檢定中外申報(bào)差異分析系列一:微生物檢查篇 6258次
6258次 2025-04-16
2025-04-16
21世紀(jì)是生物科學(xué)蓬勃發(fā)展的年代,各類生物制品成為許多生物科技公司一大重點(diǎn)研發(fā)領(lǐng)域,包括重組蛋白與抗體產(chǎn)品、mRNA產(chǎn)品、基因治療產(chǎn)品、CAR-T產(chǎn)品、疫苗產(chǎn)品等等,無(wú)不例外涉及到細(xì)胞建庫(kù)的問題。
細(xì)胞庫(kù)建立與充分的檢定對(duì)后續(xù)藥物研發(fā)以及商業(yè)生產(chǎn)環(huán)節(jié)都至關(guān)重要,能確保生產(chǎn)的可持續(xù)性及產(chǎn)品的一致性,細(xì)胞庫(kù)被污染將直接影響產(chǎn)品的安全性,同時(shí)給企業(yè)帶來(lái)巨大的損失。
中國(guó)、美國(guó)、歐洲等藥典明確規(guī)定必須對(duì)細(xì)胞庫(kù)進(jìn)行充分檢定后才可用于生產(chǎn),同時(shí)也是CDE和FDA審查的必審項(xiàng)目,需高度重視。
華微檢測(cè)結(jié)合中外法規(guī)和實(shí)際案例,對(duì)生物制品的細(xì)胞庫(kù)檢定內(nèi)容歸納解讀為三部分:微生物檢查篇、內(nèi)外源病毒檢查篇、特異性病毒檢查篇。
本篇將詳細(xì)介紹微生物檢查部分。
微生物檢查又包括細(xì)菌、真菌檢查、分枝桿菌檢查以及支原體檢查,其中細(xì)菌、真菌檢查、分枝桿菌檢查屬于無(wú)菌檢查,其主要的檢測(cè)依據(jù)為《中國(guó)藥典》2020年版 三部通則 1101無(wú)菌檢查法。無(wú)菌檢查法系用于檢查藥典要求無(wú)菌的藥品、生物制品、醫(yī)療器械、原料、輔料及其他品種是否無(wú)菌的一種方法。
值得注意的是,若供試品符合無(wú)菌檢查法的規(guī)定,僅表明了供試品在該檢驗(yàn)條件下未發(fā)生微生物污染。
目前USP、EP的無(wú)菌檢查法已通過(guò)ICH完成協(xié)調(diào)一致,《中國(guó)藥典》2020年版的無(wú)菌檢查法與他國(guó)藥典的各項(xiàng)主要參數(shù)基本也一致,主要差異點(diǎn)見表1:
表1 不同藥典里無(wú)菌檢查法的差異分析

華微檢測(cè)可參照《中國(guó)藥典》(2020版)三部通則1101無(wú)菌檢查法在B+A環(huán)境中進(jìn)行無(wú)菌檢查,可提供薄膜過(guò)濾法和直接接種法,如下圖1:

銅綠假單胞菌

金黃色葡萄球菌
黑曲霉

陰性對(duì)照
圖1 無(wú)菌檢查圖示
2020年版《中國(guó)藥典》指出主細(xì)胞庫(kù)、工作細(xì)胞庫(kù)、病毒種子批、對(duì)照細(xì)胞以及臨床治療用細(xì)胞進(jìn)行支原體檢查時(shí),應(yīng)同時(shí)進(jìn)行培養(yǎng)法和指示細(xì)胞培養(yǎng)法(DNA染色法)。病毒類疫苗的病毒收獲液、原液采用培養(yǎng)法檢査支原體,必要時(shí),亦可采用指示細(xì)胞培養(yǎng)法篩選培養(yǎng)基。也可采用經(jīng)國(guó)家藥品檢定機(jī)構(gòu)認(rèn)可的其他方法。
培養(yǎng)法作為支原體檢測(cè)的金標(biāo)準(zhǔn),在中國(guó)藥典、美國(guó)藥典和歐洲藥典中都是作為基本的檢測(cè)方法而使用,其之間的主要差異點(diǎn)如表2~3:
表2 不同藥典里對(duì)支原體檢查中培養(yǎng)法的要求

表3 不同藥典里對(duì)支原體檢查中指示細(xì)胞培養(yǎng)法的要求

華微檢測(cè)可參照《中國(guó)藥典》(2020版)三部通則3301支原體檢查法的要求進(jìn)行,可提供符合法規(guī)要求的支原體檢查,包括培養(yǎng)法和指示細(xì)胞培養(yǎng)法,培養(yǎng)法檢測(cè)的靈敏度高于中國(guó)藥典要求,肺炎支原體達(dá)到10-9,口腔支原體達(dá)到10-5,如下圖2~5:

圖2 肺炎支原體培養(yǎng)基靈敏度檢查(從左到右分別10-7、10-8、10-9(各3管),陰性對(duì)照)

圖3 口腔支原體培養(yǎng)基靈敏度檢查(從左到右分別10-3、10-4、10-5(各3管),陰性對(duì)照)

圖4 熒光顯微鏡下的肺炎支原體

圖5 熒光顯微鏡下的口腔支原體
華微檢測(cè)細(xì)胞庫(kù)檢定服務(wù)
華微檢測(cè)實(shí)驗(yàn)室配備有多間加強(qiáng)型生物安全二級(jí)實(shí)驗(yàn)室(P2),已在廣州市備案,實(shí)驗(yàn)室按照GMP質(zhì)量體系運(yùn)行,且通過(guò)CMA、CNAS評(píng)審,B+A環(huán)境,滿足無(wú)菌及相關(guān)病毒檢測(cè)的環(huán)境要求。
遵循FDA、CHP、EP、ICH等多個(gè)國(guó)內(nèi)外法規(guī)和指導(dǎo)原則進(jìn)行設(shè)計(jì),建立了全面的細(xì)胞庫(kù)檢定操作規(guī)程,主要包括以下幾個(gè)方面:細(xì)胞鑒別、無(wú)菌檢查、支原體檢查、內(nèi)外源病毒因子檢查、成瘤性/致瘤性檢查、染色體檢查等。
檢測(cè)項(xiàng)目及方法見下表4:

- 服務(wù)范圍
生物制品服務(wù)工作站 +
廣州開發(fā)區(qū)廣州市黃埔區(qū)生物制品行業(yè)質(zhì)量基礎(chǔ)設(shè)施服務(wù)工作站
特色檢測(cè)服務(wù) +
微生物制劑評(píng)價(jià)
抗菌抗病毒藥物篩選
抗生素效價(jià)檢測(cè)
醫(yī)療器械檢測(cè) +
醫(yī)用敷料檢測(cè)
醫(yī)用輸注器具及醫(yī)用導(dǎo)管檢測(cè)
藥械組合醫(yī)療器械檢測(cè)
醫(yī)美產(chǎn)品檢測(cè)
生物制品檢測(cè) +
細(xì)胞庫(kù)檢測(cè)
生物制品批放行檢查/型式檢查
細(xì)胞內(nèi)外源病毒因子檢查
原輔料、培養(yǎng)基、耗材檢查
工藝雜質(zhì)殘留研究
微生態(tài)制劑(活菌制劑)檢查
非臨床研究與生物樣本檢測(cè) +
藥代動(dòng)力學(xué)研究
藥效學(xué)研究
皮膚外用制劑透皮吸收研究
樣本分析檢測(cè)
病毒中和抗體檢測(cè)
藥品檢測(cè) +
藥品、原輔料理化檢查
藥品微生物檢查
效價(jià)與生物學(xué)活性
抗菌/抗病毒藥物篩選
藥包材檢測(cè)
病毒殺滅檢測(cè) +
凈化產(chǎn)品病毒去除性能測(cè)試
消毒產(chǎn)品病毒滅活效果測(cè)試
日化輕工材料抗病毒效果測(cè)試
精品定制化測(cè)試
食品/保健食品檢測(cè) +
食品保健品毒理學(xué)檢測(cè)
食品保健品功效評(píng)價(jià)研究
其它定制化服務(wù)
其他檢測(cè)服務(wù) +
化妝品原料毒理檢測(cè)
化妝品體外功效評(píng)價(jià)
化妝品/美容儀體內(nèi)外透皮吸收評(píng)價(jià)
實(shí)驗(yàn)動(dòng)物飼/寄養(yǎng)服務(wù)
動(dòng)物誘發(fā)性造模
儀器設(shè)備共享服務(wù)
分子生物學(xué)實(shí)驗(yàn)技術(shù)服務(wù)平臺(tái)
ELISA實(shí)驗(yàn)技術(shù)服務(wù)
熒光定量PCR實(shí)驗(yàn)技術(shù)服務(wù)
Western Blotting實(shí)驗(yàn)技術(shù)服務(wù)
外源性生物殘留檢測(cè)服務(wù)平臺(tái)
病毒核酸參考品服務(wù)
- 聯(lián)系我們
- 聯(lián)系人:史工18928790749、嚴(yán)工
- 手機(jī):19924323595、020-82118202、020-31608627【微信同號(hào)】
- 微信號(hào):
掃碼添加史工 掃碼添加嚴(yán)工
- 郵箱:yanyongxian@gdhvt.com
- 地址:廣州市黃埔區(qū)攬?jiān)侣?號(hào)F棟316(總部)廣州市黃埔區(qū)科學(xué)城尖塔山路1號(hào)(動(dòng)物中心)

 為您推薦更多
為您推薦更多

掃碼添加史工 掃碼添加嚴(yán)工
聯(lián)系人:史工18928790749、嚴(yán)工
聯(lián)系電話:19924323595、020-82118202、020-31608627
地址:廣州市黃埔區(qū)攬?jiān)侣?號(hào)F棟316(總部)廣州市黃埔區(qū)科學(xué)城尖塔山路1號(hào)(動(dòng)物中心)
版權(quán)所有 ? 廣東省華微檢測(cè)股份有限公司- 生物制品服務(wù)工作站
- 特色檢測(cè)服務(wù)
- 醫(yī)療器械檢測(cè)
- 生物制品檢測(cè)
- 非臨床研究與生物樣本檢測(cè)
- 藥品檢測(cè)
- 病毒殺滅檢測(cè)
- 食品/保健食品檢測(cè)
- 其他檢測(cè)服務(wù)
- 細(xì)胞庫(kù)檢測(cè)
- 生物制品批放行檢查/型式檢查
- 細(xì)胞內(nèi)外源病毒因子檢查
- 原輔料、培養(yǎng)基、耗材檢查
- 工藝雜質(zhì)殘留研究
- 微生態(tài)制劑(活菌制劑)檢查
- 化妝品原料毒理檢測(cè)
- 化妝品體外功效評(píng)價(jià)
- 化妝品/美容儀體內(nèi)外透皮吸收評(píng)價(jià)
- 實(shí)驗(yàn)動(dòng)物飼/寄養(yǎng)服務(wù)
- 動(dòng)物誘發(fā)性造模
- 儀器設(shè)備共享服務(wù)
- 分子生物學(xué)實(shí)驗(yàn)技術(shù)服務(wù)平臺(tái)
- ELISA實(shí)驗(yàn)技術(shù)服務(wù)
- 熒光定量PCR實(shí)驗(yàn)技術(shù)服務(wù)
- Western Blotting實(shí)驗(yàn)技術(shù)服務(wù)
- 外源性生物殘留檢測(cè)服務(wù)平臺(tái)
- 病毒核酸參考品服務(wù)
-




 立即咨詢
立即咨詢 留言咨詢
留言咨詢



